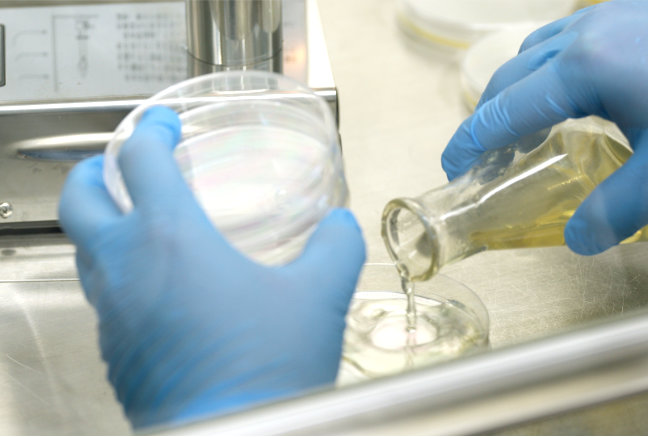
company10.jpg

雪芝サプリメント健康食品を選ぶならパワフル健康食品!霊芝(レイシ)、アガリクス(姫マツタケ)からプロテオグリカンゼリーサプリまで健康対策トータルサポート。創立42年、医学薬学博士・ドクターが顧問の信頼実績。独自の特許製法を用いた健康食品が、家族・会社・地域を守れる健康力と全力で挑める毎日、明日の自信を応援します。
こんなお悩みありませんか?
現代人の健康に欠かせない存在となっている健康食品

健康食品ってどれを飲んでも同じなんでしょ?

イイモノと安物の違いがわからない...

怪しい商品に騙されたらどうしよう.....
\そんな不安から解消され安心して飲み続けられます/

パワフル健康食品(株)の霊芝・姫マツタケが
長年愛され続けている3つのポイント

1:創業42年の研究年数と健康を願う想い
人も食物も無限の可能性を持っています。
その魅力を引き出せるのも私たちの積極的精神と努力です。
茸は同じ種類であっても菌株や栽培方法で栄養価もサポートも違います。
どれだけのメリットがあるのか、どんな栽培や製造方法がよいのか、約40年に渡る長年の研究と実績を積み重ね、霊芝は長野県で栽培、姫マツタケはパラグアイで栽培し日本で管理し、自信をもって世界中にお届けできる製品となっております。
そして人は健康だからこそより一層の楽しみや挑戦があります。
自分も飲みたいか?家族にも飲んでもらいたいか?本当にサポート役になるのか 弊社では心身共に健康力を育み無限の可能性に挑戦できる健康社会づくりに貢献したいため開発しております。
写真:中田社長と細胞壁破壊霊芝の製造法を一緒に開発した東京大学名誉教授(故)善本先生

2:特許取得済みの製造方法で製造
茸の細胞は普通の破砕作業では得ることができない食品の成分があります。
・消化しにくい
・水抽出できない
・アルコール抽出できない
そこで食品の全体(ホールフーズ理論)を食すことが出来る当社でしか製造することが出来ない 細胞壁破壊特許製造方法で、キノコの細胞の壁を壊し中から栄養成分を取り出すという 技術を用い霊芝と姫マツタケ製品を製造しております。

3:ISO22000:2018そして健康補助食品GMP認証取得で安心安全
食の安全性は世界の共通課題でもあります。
弊社ではHACCPも組み込まれたISO22000:2018 と、海外輸出には欠かせない健康補助食品GMPの両方を認証取得しております。
原料の管理から工程ごとに品質の確認を行っておりますので 安心してお召し上がりいただけます。
長年愛され続けるパワフル健康食品(株)
開発商品一覧

霊芝の研究一筋50年
弊社では2007年に食品業界に先駆け、HACCPとISO9001を包括した食品安全マネジメントシステムである、ISO22000に続き、2009年には安全・安心な食品製造規範である、健康補助食品GMPを取得しました。
これを機に茸関連のみならず、総合食品製造メーカーとして広く、お客様の満足お答えできます様、安心安全な食品の開発、提供を責務とし、自然の大切さ食への感謝、更には、心と身体のバランスは「食に有り」をモットーとし。人類のみならず植物・生物・すべての生命活動にお役に立てます様、グローバルな目的を持った企業として社会に貢献してまいります。
パワフル健康食品の研究にご協力いただいている学術顧問の先生
中田社長の想いに賛同し、
各分野の学術顧問を引き受けていただいております。
 伊藤 均
伊藤 均
医学薬学博士
 米山 誠
米山 誠
 高良 毅
高良 毅
タカラクリニック院長
認可を受けたISO22000と健康補助食品GMPについて
品質保証と認証について
パワフル健康食品(株)本社工場
ISO22000:2018・健康補助食品GMP共に認証取得して終わりではありません。
厳しい品質管理の中でより安心してお召し上がりいただけるように日々の確認や検証を行いながら認証も更新し続けております。


心身共に健康力を育み
無限の可能性に挑戦できる
幸福健康社会づくりに貢献します
弊社は1982年に現在のパワフル健康食品株式会社を設立、本格的に茸のトータルメーカーとして食品業界に参入。
1996年に世界で初めて茸の細胞壁を壊し、有用成分の利用を可能にした技術を開発したり農産物の乳酸菌発酵も含め特許を取得し
SDGsの先駆けとしても世界に誇れる健康食品メーカーを目指しISO22000、健康補助食品GMPの認証取得しながら
時代や環境の変化が激しくても常に安心・安全性・質の担保・生産性の向上を追求し、モノづくりへの技術と新しい発想を磨き続け、
共に成長しあえるよう提案と丁寧親切な思いやりを大切に社会に貢献できる企業を目指しております。
代表取締役 中田 福佳(プロフィール)
健康食品サプリメントの総合メーカー
パワフル健康食品を紹介します
 自然豊かな信州・長野県信濃町で製造
自然豊かな信州・長野県信濃町で製造
また黒姫山・飯縄山・戸隠山・妙高山・斑尾山という北信5岳に囲まれ鳥をはじめ自然の音色が響く田畑の中に弊社があります。
品質管理の徹底
品質管理の徹底
安心してお客様に毎日食べていただけるよう、自社内に研究開発専門のバイオ工場を設置し、安全性の確認と厳しい品質管理の中で健康を願い製造しております。
 日本で初めて人工栽培に成功した直井霊芝
日本で初めて人工栽培に成功した直井霊芝
そして長野県での栽培だけでなく霊芝の細胞の壁の内側から有用成分を取りだすという技術も特許を取得しました。
その後霊芝は長野県で自社栽培しており、煮詰めたりただ乾燥粉砕するだけではないメリットから長年愛され続けております。
 感謝と喜び、世の為人のためになることを常に考え実行する
感謝と喜び、世の為人のためになることを常に考え実行する
健康食品サプリメントの受託製造OEM・ODM総合メーカーとして企画・配合提案・試作含め臨機応変にご対応いたします。。
時代や環境が変わっても、健康事業で社会に貢献したいという想いは益々強くなり、社内社外研修も続け常に意識を高めあい、これからも安心安全な健康食品サプリメントをお届けいたします。












